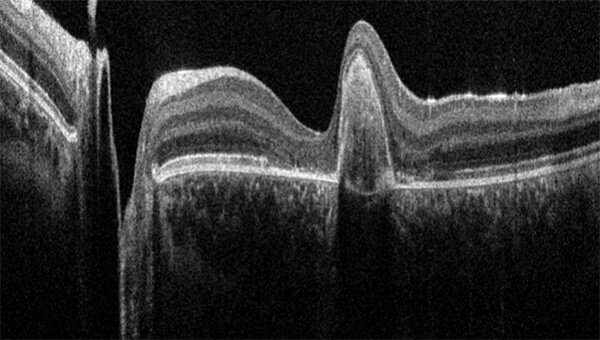

眼科
眼科手术需要高度精确才能在操作器械和处理脆弱的眼组织时确保最佳准确性。手术显微镜 是眼科手术中最重要的仪器之一,它能让眼科术者看到显微解剖结构,并执行高效且极其精确 的移动。
徕卡显微系统有限公司提供一系列先进的眼科显微技术解决方案,支持眼科术者在眼前节和眼后节手术中实现最佳治疗效果。我们的眼科显微镜享誉全球,配备精良的高端光学器件和照明系统,能提供出色的图像质量。这些显微镜旨在确保手术室中手术流程流畅顺利,并支持人体工效学, 能够在手术的各个环节以最佳方式响应术者需求。
徕卡眼科显微镜无缝集成光学相干断层扫描成像 (OCT)以及高分辨率显示和记录功能等先进的成像技术,构成了整个眼科成像和流程解决方案的平台。
眼科显微镜解决方案
手术显微镜
由始至终,白内障手术进展顺利
眼科显微镜在白内障手术的所有步骤中为眼科 术者提供支持,使他们能够高效、高精度地完成手术。
为了在白内障手术中获得清晰可视化,必须使用稳定且明亮的红光反射保持最佳照明。此外,达到充分的深度知觉也至关重要,这样可以避免在手术期间反复重新调焦,进而导致不必要的手术流程中断。
最后,显微镜采用可以定制附件的灵活设计,符合人体工效学,可提高术者舒适度,降低疲劳感,让术者专注于手术,有助于改善治疗效果。
红光反射在联合视网膜手术中的重要性
André Maia 医生是巴西圣保罗视网膜诊所的医学博士,他描述了 Proveo 8 眼科显微镜如何在联合视网膜手术中,尤其是水分离步骤和超声乳化步骤中提供卓越而稳定的红光反射。
视频演示了在超声乳化和皮质清除过程中前房和晶状体后囊膜的清晰视图。
此外,由于采用了创新的 FusionOptics 融合光学技术,整个手术过程中无需重新调焦。使用 Proveo 8,用户还可以为其手术的每个步骤预设个性化设置,实现高效、高精度手术。
眼科手术显微镜的实用附件
眼后节手术的挑战
执行眼后节手术时,术者需要在不必频繁重新调焦的情况下,透过玻璃体清晰地看到视网膜的每一处结构。在眼后节手术中,有些最为艰巨的挑战包括:
在视网膜玻璃体手术的低亮度照明条件下高精度完成手术
确保可视化的充分照明,并同时避免光毒性曝光带来的风险
保持视网膜的清晰可视化,尤其在使用广角观察系统时
在剥膜或血管缝合期间,区分不同的组织层
在剥膜过程中评估膜张力程度,避免撕裂并保护表层下组织的完整性
在剥膜过程中,获得清晰的膜层可视化
Proveo 8 高端眼科显微镜在视网膜手术中赖以为术者提供支持的优势
FusionOptics 融合光学技术,将高分辨率和大景深相结合,无需反复调焦即可清晰呈现细节丰富的细微结构,打破视野局限
视网膜玻璃体手术或玻璃体切除术的眼后节预设模式有助于术者保持聚焦。只需轻踩脚踏开关,显微镜就能自动调节。
BIOM* 眼底观察系统具有同步聚焦功能,可在视网膜玻璃体手术中进一步支持您的可视化和流程。
选择眼科手术显微镜时的重要考虑因素
从诊断到眼部手术,眼科显微镜在所有眼科治疗中都发挥着至关重要的作用。在选择眼科手术显微镜时,应予以考虑的一些最重要因素包括:
通过 OCT 引导的眼科手术获得更深入的洞察力
在视网膜、角膜和青光眼手术中,术者通常会在某个时刻问自己:我是否真的要这样做?尽管显微镜视图可以精确呈现手术部位的画面,但表层下组织的细微结构并不容易看清。
往往会产生诸如下列疑问:
是否有残留的视网膜下液?
青光眼引流装置是否正确就位?
角膜移植片是否与宿主角膜完全相对?
EnFocus 术中 OCT 系统内置于 Proveo 8 显微镜中,能在术中即时确认这些问题,帮助术者克服不确定性。关于 EnFocus 的更多信息,请单击此处。
光学相干断层扫描仪(0CT成像)
徕卡光学相干层析成像(OCT)系统以简单易用的高品质成像技术为眼科医生、眼科主刀医生和研究人员提供支持。临床前 OCT解决方案可在眼部疾病研究方面提供深入见解,而临床 OCT 系统可作为诊断病理状况的辅助手段。
白内障手术
当眼睛的晶状体变得混浊时,眼科医生会诊断患有白内障。当正常透明的晶状体蛋白质变性而发生混浊时,就会出现白内障。通常,白内障会随着年龄的增长而加剧,但这也可能是由糖尿病等基础性疾病引起的。白内障可能会影响视力,甚至导致失明。目前,手术是治疗白内障的唯一方法。